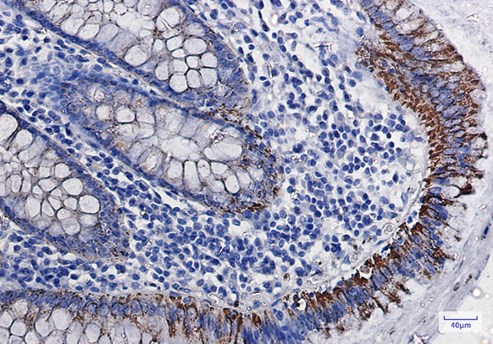
IHC analysis. (Creative Biolabs Original)

Anti-MAOA Recombinant Antibody Products
 Loading...
Loading...Anti-MAOA Products
 Loading...
Loading...- Recombinant Mouse Anti-MAOA Monoclonal Antibody (5D1) (MRO-0960-CN)
-
- Species Reactivity: Human
- Type: Mouse IgG1
- Application: WB, IF
- Rabbit Anti-MAOA Polyclonal Antibody (MRO-2040-CN) (MRO-2040-CN)
-
- Species Reactivity: Human, Mouse, Rat
- Type: Rabbit IgG
- Application: WB, IHC
-
- Species Reactivity: Human
- Type: Rabbit IgG
- Application: ELISA, IHC, IF
-
- Species Reactivity: Human, Mouse, Rat
- Type: Rabbit IgG
- Application: WB, IHC-P
- Mouse Anti-MAOA Recombinant Antibody (clone 2G1) (MOB-2125z)
-
- Derivation: Mouse
- Species Reactivity: Human
- Type: Mouse IgG1
- Application: WB, IHC
-
- Derivation: Phage display library screening
- Species Reactivity: Human
- Type: IgG
- Application: WB, IHC, ICC
-
- Species Reactivity: Human, Mouse, Rat
- Type: Rabbit IgG
- Application: WB, IHC-P, ICC, IF, FC
- Anti-MAOA Immunohistochemistry Kit (VS-0525-XY4191)
-
- Species Reactivity: Human
- Target: MAOA
- Application: IHC
- Anti-Mouse MAOA Immunohistochemistry Kit (VS-0525-XY4192)
-
- Species Reactivity: Human, Mouse, Rat
- Target: MAOA
- Application: IHC
- Anti-Rat MAOA Immunohistochemistry Kit (VS-0525-XY4193)
-
- Species Reactivity: Human, Mouse, Rat
- Target: MAOA
- Application: IHC
Can't find the products you're looking for? Try to filter in the left sidebar.Filter By Tag
Our customer service representatives are available 24 hours a day, from Monday to Sunday. Contact Us
For Research Use Only. Not For Clinical Use.
Are prolonged development cycles and inconsistent antibody performance hindering your neuropharmacology research? Creative Biolabs' anti-MAOA recombinant antibodies leverage advanced recombinant engineering and stringent validation protocols to deliver unmatched specificity and reproducibility. These tools streamline target validation, reduce optimization time, and empower robust data generation for preclinical development.
MAOA: A Critical Regulator of Neurotransmitter Homeostasis
Amine oxidase [flavin-containing] A (MAOA) is a mitochondrial enzyme pivotal in catalyzing the oxidative deamination of monoamine neurotransmitters, including serotonin, norepinephrine, and dopamine. Dysregulated MAOA activity is implicated in depression, aggression, and neurodegenerative disorders, making it a high-value therapeutic and diagnostic target.
Alternative Names
MAO-A; MAOA; Monoamine oxidase A; Amine oxidase [flavin-containing] A.
Background
This gene is one of two neighboring gene family members that encode mitochondrial enzymes which catalyze the oxidative deamination of amines, such as dopamine, norepinephrine, and serotonin. Mutation of this gene results in Brunner syndrome. This gene has also been associated with a variety of other psychiatric disorders, including antisocial behavior. Alternatively spliced transcript variants encoding multiple isoforms have been observed. [provided by RefSeq, Jul 2012]
Disease related genes, Enzymes, FDA approved drug targets, Human disease related genes, Metabolic proteins
Membrane
Cell type enhanced (Proximal enterocytes, Proximal tubular cells, Undifferentiated cells)
Not detected in immune cells
Cell line enhanced (ASC diff, HHSteC, HSkMC, hTCEpi, RT4)
Monomer, homo- or heterodimer (containing two subunits of similar size). Each subunit contains a covalently bound flavin. Enzymatically active as monomer.
Oxidoreductase
Anti-MAOA rAb Products
Creative Biolabs' anti-MAOA recombinant antibodies are engineered for high-affinity binding across human and model species. Optimized for functional assays, IHC, and therapeutic target screening, these biologics enable precise interrogation of MAOA-mediated pathways in neurological and oncological research.
| Cat. No. | Product Name | Target Species | Host Species | Applications |
| MOB-2125z | Mouse Anti-MAOA Recombinant Antibody (clone 2G1) | Human | Mouse | WB, IHC |
| VS3-FY874 | Recombinant Rabbit Anti-MAOA Antibody (clone R07-9I3) | Human, Mouse, Rat | Rabbit IgG | WB, IHC-P |
| ZG-0109U | Rabbit Anti-MAOA Recombinant Antibody (clone 4C11) | Human | Rabbit IgG | ELISA, IHC, IF |
| MRO-2040-CN | Rabbit Anti-MAOA Polyclonal Antibody (MRO-2040-CN) | Human | Rabbit IgG | WB, IHC |
| MRO-0960-C | Recombinant Mouse Anti-MAOA Monoclonal Antibody (5D1) | Human | Mouse | WB, IF |
Table.1 Featured anti-MAOA recombinant antibody product at Creative Biolabs.
Creative Quality Control
Each anti-MAOA recombinant antibody undergoes rigorous validation via ELISA, Western blot, and functional inhibition assays. Lot-to-lot consistency is ensured through mass spectrometry profiling and kinetic binding analysis (SPR), guaranteeing reliable performance in complex biological matrices.
 Fig.1 IF analysis of anti-MAOA antibody.
Fig.1 IF analysis of anti-MAOA antibody.
(Cat# MOB-2125z, Creative Biolabs).
 Fig.2 WB result of anti-MAOA antibody.
Fig.2 WB result of anti-MAOA antibody.
(Cat# VS3-FY874, Creative Biolabs).
Fig.3 IHC results of anti-MAOA antibody.
Fig.3 IHC results of anti-MAOA antibody.
(Cat# VS3-FY874, Creative Biolabs).
 Fig.4 IHC staining result of anti-MAOA antibody.
Fig.4 IHC staining result of anti-MAOA antibody.
(Cat# ZG-0109U, Creative Biolabs).
Customer Reviews

Mouse Anti-MAOA Recombinant Antibody (clone 2G1)

Rabbit Anti-MAOA Polyclonal Antibody (MRO-2040-CN)

Rabbit Anti-MAOA Recombinant Antibody (clone 4C11)
rAb Production
Our chemically defined mammalian expression platform enables accurate post-translational processing and supports production scalability from milligram to gram quantities. By coupling AI-assisted codon optimization with state-of-the-art perfusion bioreactor systems, we consistently attain >95% monomeric purity—crucial for both in vivo applications and diagnostic reliability.
Featured Anti-MAOA Recombinant Antibody Production Platforms
Fig.5 Production of recombinant anti-MAOA antibodies at milligram scale.
 Fig.6 Gram-level expression of MAOA-directed recombinant antibodies.
Fig.6 Gram-level expression of MAOA-directed recombinant antibodies.
rAb Modalities
Customize your research with formats spanning scFv, bispecific antibodies, and Fc-engineered variants. These modalities support diverse applications, including live-cell imaging, multi-omics profiling, and in vivo therapeutic efficacy studies.
 Fig.7 Approaches for the generation of full-length recombinant antibodies against MAOA.
Fig.7 Approaches for the generation of full-length recombinant antibodies against MAOA.
Creative Biolabs bolsters your research by supplying premium anti‑MAOA recombinant antibodies, underpinned by our relentless pursuit of scientific innovation and unwavering commitment to client success. For inquiries or bespoke project consultations, please reach out—our team of experts stands ready to empower your investigative goals.


 Amphetamine Addiction
Amphetamine Addiction